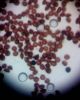

|
|
||||||||||||||||||||||||||||||
Pēdējie novērojumi
Peļkājīte
Prunella modularis - 2026-05-15 grieze
Paceplītis
Troglodytes troglodytes - 2026-05-15 grieze
Lakstīgala
Luscinia luscinia - 2026-05-15 grieze
Sarkanrīklīte
Erithacus rubecula - 2026-05-15 grieze
Žubīte
Fringilla coelebs - 2026-05-15 grieze
Meža pīle
Anas platyrhynchos - 2026-05-15 grieze
Melnais mušķērājs
Ficedula hypoleuca - 2026-05-15 grieze
|
Pēdējie komentāri novērojumiem
Ziemelmeita guta7 Julita, paldies par ieguldījumu gļotsēņu noteikšanā! adata adata Šis bija otrs atliktais [un aizmirstais] paraugs. Hipotēze apstiprināta :) Šis laikam tāds starpposms, ko es no foto pagaidām neizšķiršos noteikt. Drīzāk H.calyculata Nu tātad apkakles palampītei mēdz būt tik gara kājiņa :) adata Julita, šai ir aizsūtīts paraugs. Jo tad šī būtu jauna suga Latvijai mufunja mufunja Varbūt man ir daļa no parauga, man jāaplūko:) Šīs tā arī palika nemikroskopētas? Droši kocītes, nevis cilindrītes? Foto saprast nevar Varbūt Comatricha laxa. Ja būtu labāki foto, varbūt varētu droši pateikt. Ja garums vismaz 2 mm, tad C.nigra VijaS Paldies, Julita, par visiem labojumiem! :) Skaitās sugu grupa. Varbūt kādreiz sadalīs un varēs pārskatīt, jo kapilīcijs ar kārpām nav tipisks. adata Paldies, Julita, par šo - tā arī es domāju, un par visām citām līdz šim noteiktajām! Pēc mikroskopijas arī nešaubīga olīšu aplocīte :) Vai nav pārāk izstieptas priekš denudata sardelīšu būtu izlocītas, bet te garas un paralēlas vālītes Neesmu droša, ka 2. foto ir tā pati suga. Ja nu traumēta KURSA1 25.aprīlis, 11:12 Vīksna Ozolu vērpējsprīžmetis, Biston strataria. Uz to pusi ir, bet augļķermeņi dikti izlocīti. Drīzāk teiktu, ka no vēl neaprakstīto sugu grupas V.Grigorjevs lb. kāja tomēr drīzāk izskatās pēc "zils virs melna" (+krāsas nodilums), tad LV. V.Grigorjevs adata Ziemelmeita mufunja mufunja mufunja mufunja Atradīšu paraugu un uztaisīšu. mufunja Tur to bija tik daudz un dažādās brieduma pakāpēs:( Augšējos 2 foto drīzāk kāda cita suga Jā, ļoti tumša, tomēr tonis sarkanīgs un sporas atbilst. Eggy Lauzts spārns, uzturas šajā vietā jau vairākas dienas. Jā, Iveta, te jautājums ir, vai dzīvs. mufunja Noteikti alksnis. Neesmu pārbaudījis, vai tas ir dzīvs vai nē. mufunja Koks bija dzīvs, to es atceros. Mežs bija blīvs, pārsvarā alksnis. Mitrs, netālu no upes. adata Manā skatījumā tas ir, ja ne alksnis, tad lapu koka noteikti. mufunja Nevarēju uzņemt labāku fotoattēlu. Viss ir tik gaišs:( Kas ar šo ir domāts? Lūdzu skaidrojumu. Te arī būtu svarīgi zināt, vai dzīvs koks, un vai tur bija mežs. Netradicionāls sporu izmērs. mufunja Par alksni neko nevaru teikt, nepievērsu uzmanību :( mufunja mufunja Es tā nedomāju. Tas aug uz alkšņa. Tas drīzāk izskatās pēc Badhamia. Izskatās, ka redzami arī tukši “trauciņi”. Šo vajadzētu šonedēļ mikroskopēt! Physarum cf. diderma? W W Ļoti līdzīga ir Macbrideola herreraem bet tai kājiņas apakša būtu sarkana. erihir Paldies, of course, did not check moult when I uploaded photo. Marina, šo novērojumu vajag sadalīt, vai arī pēdējos divus foto izdzēst Ja ir kājiņa, tad teiktu, ka T.decipiens kamene Ziemelmeita Paldies,Ansi, par sugu noteikšanu. Vīksna tomhi Flowers and leaves definitely G. densiflora tomhi Flowers and leaves definitely G. densiflora tomhi Flowers definitely G. densiflora tomhi Flowers and leaves definitely G. densiflora tomhi Flowers definitely G. densiflora tomhi Flowers and leaves definitely G. densiflora tomhi Flowers and leaves definitely G. densiflora Tomēr vēl būs pēcsniedzīte! :) tomhi Flowers definitely G. densiflora. tomhi Flowers definitely G. densiflora tomhi Flowers definitely G. densiflora tomhi Flowers definitely G. densiflora tomhi Flowers definitely G. densiflora tomhi Flowers and leaves definitely G. densiflora Ivetta guta7 Vīksna Vīksna zemesbite Zirņu rūsas (Uromyces pisi-sativi) bojāts augs. Mežirbe777 Kaut kas sajaukts? Domāts Pulmonaria saccharata? KM V.Grigorjevs DaceK Jā, diemžēl ir tikai šī viena bilde. Amanda Amanda Amanda 3 un 4 attēlā vidējais dzenis. Baltsvītru miežabrālis - Phalaris arundinacea fo. picta Ziemelmeita guta7 guta7 guta7 VitaS Ziemelmeita Paldies,Julita! Paraugs ir, jāmeģina atrast brīdis pie mikroskopa. Ziemelmeita Amanda Jāredz tuvāk (kaut vai izkadrēts šis pats attēls) - varbūt tumšā eļļasvabole (Meloe proscarabaeus) Ivars Leimanis Aleksejs Šarīpins 17.aprīlis, 23:37 VijaS Nē, nenobrieda līdz sporām, nesaglabāju. VijaS Bekuvecis 17.aprīlis, 15:43 InŠu 17.aprīlis, 11:47 mufunja mufunja Man kaut kā neizskatās pēc T.varia. Pēc pēdējā foto spriežot, - varētu būt paraugs? Jā, šis novērojums ļoti interesants. Žēl, ka nav skaidra plazmodija piederība. Nav pārliecības, ka te ir divi vijumi elaterai VitaP. Mežiņā pie mājām, kļavā ieurbtā caurumā (sulām). adata Siona erihir erihir Paldies, and sorry! I am struggling with latin-Latvian, species is of course leucopsis. Mežirbe777 Jāatdala, gan jau nav parastais Lietuviete Vladimirs S Ziemelmeita Paldies, Julita, par skaidrojumu. Noteikti nav Chaenotheca stemonea. Tā ir ar zaļu laponi, brūnu sporu masu. Jābūt vēl vienam simbolam, kas lasās perpendikulāri redzamajiem! Ziemelmeita Tad jau iespējams ka medainā arī apaug. Es arī īsti nezinu vai tā ir. adata Hmm, pilienīšu dzimta vien ir, par to nebiju aizdomājusies. Ko Julita teiks? adata Skaista! Šķiet, sporu masa varētu būt dzeltena. Ziemelmeita Varbūt arī Poecilus versicolor adata Teiktu, ka medainā bumbulīte. Redz vertikāli izstieptus augļķermeņus (ne pilienveida). Bet ievākts jau nav? Vērtīgs, jo ar attīstību Ziemelmeita adata Gredzenots kā pieaudzis putns 14.11.2021. Gdynia: Skwer Plymouth, POMORSKIE, POLAND. Pēc foto noteica Valdis Pilāts. Balts vēders kā klaidoņpelei, svītra pār muguru - svītrainā. Ziemelmeita adata zane_ernstreite Paldies, Julita, par apstip[rinājumu! ligausis zane_ernstreite Jā, tūlīt to arī daru, jau procesā ))) Ja novērojumu neliek caur aplikāciju, tad bildes jāpievieno pēc tam. T.i., tagad. a.b Gredzenošanas vieta: Bišumuiža, Rīga Gredzenošanas datums: 22.05.2025 a.b Amanda |